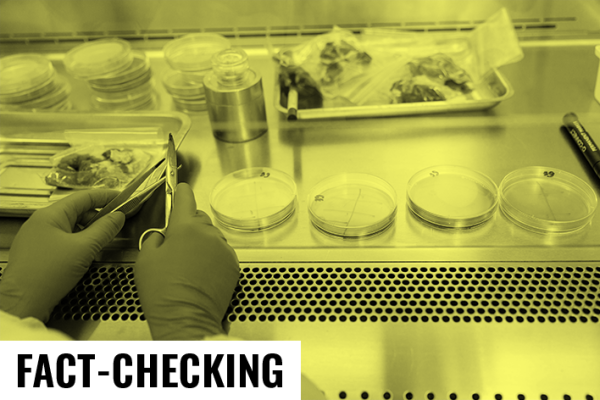

Non, rien ne prouve que les États-Unis développent secrètement des armes biologiques en Afrique
Dernière modification : 5 mai 2025
Autrice : Ella Couet, étudiante en master de journalisme à Sciences Po Paris
Relectrice : Clara Robert-Motta, journaliste
Liens d’intérêts ou fonctions politiques déclarés des intervenants à l’article : aucun
Secrétariat de rédaction : Etienne Merle, journaliste
Source : Compte Facebook, le 24 décembre 2024
Des accusations de la défense russe, selon lesquelles les États-Unis développeraient des armes biologiques dans des laboratoires africains, circulent en ligne. Il s’agirait d’une campagne de désinformation qui ne repose sur aucun élément tangible, selon plusieurs experts indépendants.
Des fonctionnaires prépareraient secrètement une guerre biologique en Afrique, pour le compte des États-Unis ? C’est l’accusation émise par un mystérieux « commandant adjoint des troupes de défense radiologique, chimique et biologique des forces armées de la Russie« , Alexeï Rtichtchev. Ce dernier, dont il n’existe aucune trace sur internet, si ce n’est au sujet de ces accusations, a tenu une conférence de presse, le 24 décembre 2024, à en croire certains sites de propagande russe.
Selon ce militaire, les États-Unis utiliseraient la région comme un “réservoir naturel illimité d’agents pathogènes et d’infections dangereuses” et un “terrain d’essai”. “La tendance est claire”, assure-t-il, “les agents pathogènes des maladies qui intéressent le Pentagone deviennent pandémiques, et les entreprises pharmaceutiques américaines en sont les bénéficiaires”.
La défense russe n’a cependant rendu public aucun élément permettant de prouver ces accusations. Seul un assemblage de documents concernant l’activité biologique des États-Unis à l’étranger, montré lors de la conférence, est accessible en ligne. Mais ils ne permettent pas à eux seuls de prouver l’existence des activités illégales dont parle la Russie. L’Afrique n’y est d’ailleurs pas mentionnée.
En plus de ces accusations d’une prétendue préparation à une guerre bactériologique, plusieurs laboratoires sur le sol africain, dans lesquels seraient menées ces recherches dangereuses, sont visés.
Ces accusations, relayées dans de nombreux médias pro-russes, ont trouvé de l’écho sur les réseaux sociaux, notamment en France, comme dans cette publication sur Facebook. Le post cite trois laboratoires qui seraient impliqués, et désigne nommément six fonctionnaires travaillant dans ces structures, ainsi que leurs fonctions et leurs lieux de résidence, car ils auraient “vendu leurs âmes au diable”. Mais sur quoi se fondent ces accusations ?
Des programmes de collaboration
Le gouvernement russe accuse les États-Unis de contrevenir à une règle internationale d’interdiction de développer des armes biologiques. Mais que sont vraiment ces laboratoires ?
À première vue, ces laboratoires, accusés par la Russie de développer des armes biologiques pour les États-Unis, ne sont pas forcément sous la tutelle du pays outre-Atlantique. “Ce sont pour la plupart des laboratoires qui collaborent et qui reçoivent des financements américains, mais qui ne dépendent pas directement des États-Unis”, éclaire Elisande Nexon, maître de recherches à la Fondation pour la Recherche Stratégique (FRS) et spécialiste des armes biologiques. Les programmes de recherche qui y sont menés viseraient à répondre à des enjeux de santé publique, en étudiant des maladies infectieuses présentes dans ces pays.
Parmi ses missions, le laboratoire de référence de défense d’Abuja (Nigéria) — dont la collaboration avec le Département états-unien de la Défense est indiquée clairement en ligne — assure ainsi “soutenir la recherche clinique et la surveillance des maladies infectieuses”, tandis que le laboratoire Kevevapi de Nairobi (Kenya), dont les recherches se concentrent sur les vaccins vétérinaires, dit “produire des vaccins vétérinaires sûrs, efficaces et abordables en menant des recherches, en fournissant des informations, en commercialisant et en distribuant des vaccins pour améliorer l’industrie de l’élevage.”
Le Walter Reed institute, un établissement qui appartient strictement à l’armée des États-Unis, cherche selon son site web à surveiller les agents pathogènes en circulation pour protéger les soldats états-uniens de la menace des maladies infectieuses endémiques. “Historiquement, les maladies ont affaibli ou tué plus de militaires que les blessures au combat”, explique l’organisme, avant de préciser : “Ces données sont ensuite utilisées pour éclairer et diriger les efforts de découverte et de développement des produits.”
“Cela fait tout à fait sens d’avoir des infrastructures de recherche dans lesquelles on peut manipuler ces agents pour faire avancer la recherche et mettre en place des moyens de prévention et de traitement au profit des populations”, commente Elisande Nexon.
L’existence de ces laboratoires, leurs activités et leurs financements, notamment états-uniens, sont d’ailleurs des informations publiques et accessibles en ligne. Selon elle, il s’agit aussi pour les États-Unis d’une manière de développer une “sorte de diplomatie scientifique et sanitaire”.
Certains laboratoires kényans, nigérians ou tanzaniens collaborent donc bien avec les États-Unis, mais les allégations de développement d’armes biologiques, émises par la Russie sans fournir de preuves pour les appuyer, semblent, elles, peu fondées. Surtout, ce type d’accusations ne date pas d’hier : “Ce genre de tentative de manipulation de l’information en partant d’éléments réels, c’est quelque chose que l’on retrouve depuis longtemps”, analyse Elisande Nexon.
Les mêmes accusations depuis des années
Le discours est identique chez Maxime Audinet, chercheur en sciences politiques à l’Institut de recherche stratégique de l’école militaire (Irsem), spécialiste de l’influence russe. “Cette accusation d’utiliser des armes biologiques est un très vieux sujet, notamment en Afrique”, indique-t-il.
“En 1983, l’opération de désinformation ‘Denver’, menée par le KGB, consistait à faire croire que le VIH avait été inventé dans un laboratoire américain pour décimer les populations gays et afro-américaines des États-Unis et les populations africaines”, raconte le chercheur. La rumeur avait été méthodiquement diffusée en Afrique pour discréditer la puissance américaine, en la rendant responsable de la création du Sida.
D’après le chercheur, la liste des opérations similaires à celles-ci serait longue. “Ces accusations fonctionnent très bien, notamment parce que le sujet des armes biologiques a un côté très choquant éthiquement”, décrypte-t-il. En effet, l’idée de maladies élaborées par des États et lâchées sur les populations se trouve au cœur de la complosphère depuis des années.
“A priori, il peut paraître loufoque que des personnes y croient, mais c’est parce que ces rumeurs sont déjà ancrées qu’elles sont mobilisées”, explique Maxime Audinet. “Ces accusations utilisent de vieux thèmes qui parlent à l’opinion publique africaine et réactivent des références précises, une sorte de mémoire de certains événements, vrais ou faux.”
Les récentes accusations émanant directement du gouvernement russe qui attaque les États-Unis au sujet des laboratoires africains s’inscrivent donc dans un contexte plus large de désinformation ciblée. Pour Elisande Nexon de la FRS, elles pourraient être le dernier épisode d’une série d’allégations russes dont les prémices remontent à 2014 ou 2015. “La campagne reprend exactement le même type d’accusations que celles formulées à cette époque par la Russie contre des laboratoires en Géorgie et au Kazakhstan, puis en Ukraine à partir de 2022”, explique la chercheuse aux Surligneurs.
Même son de cloche chez Maxime Audinet, pour qui les récentes accusations d’Alexeï Rtichtchev relèvent d’une nouvelle campagne de désinformation russe, qui pourrait être coordonnée. Leur diffusion serait d’ailleurs facilitée par l’écosystème d’influence russe en Afrique, qui comprend énormément d’acteurs : à la fois des médias d’État russes, comme Sputnik ou RT, et des acteurs locaux externalisés qui se mettent au service de la propagande russe.
La prétendue conférence de presse, d’Alexeï Rtichtchev sur les activités biologiques des États-Unis en Afrique a en effet été relayée par de nombreux sites d’information favorables au régime russe dans une série d’articles au contenu identique, comme sur Sputnik Afrique et Pravda, et reprises par quelques médias africains, comme le journal béninois La Nouvelle Tribune.
“L’écosystème russe s’insère dans les écosystèmes locaux pour « viraliser » ce type de contenu”, résume Maxime Audinet. La Russie semble habituée à utiliser la question des armes biologiques pour accuser ses adversaires, mais rien ne permet de penser qu’elle dispose d’éléments tangibles pour étayer ses accusations.